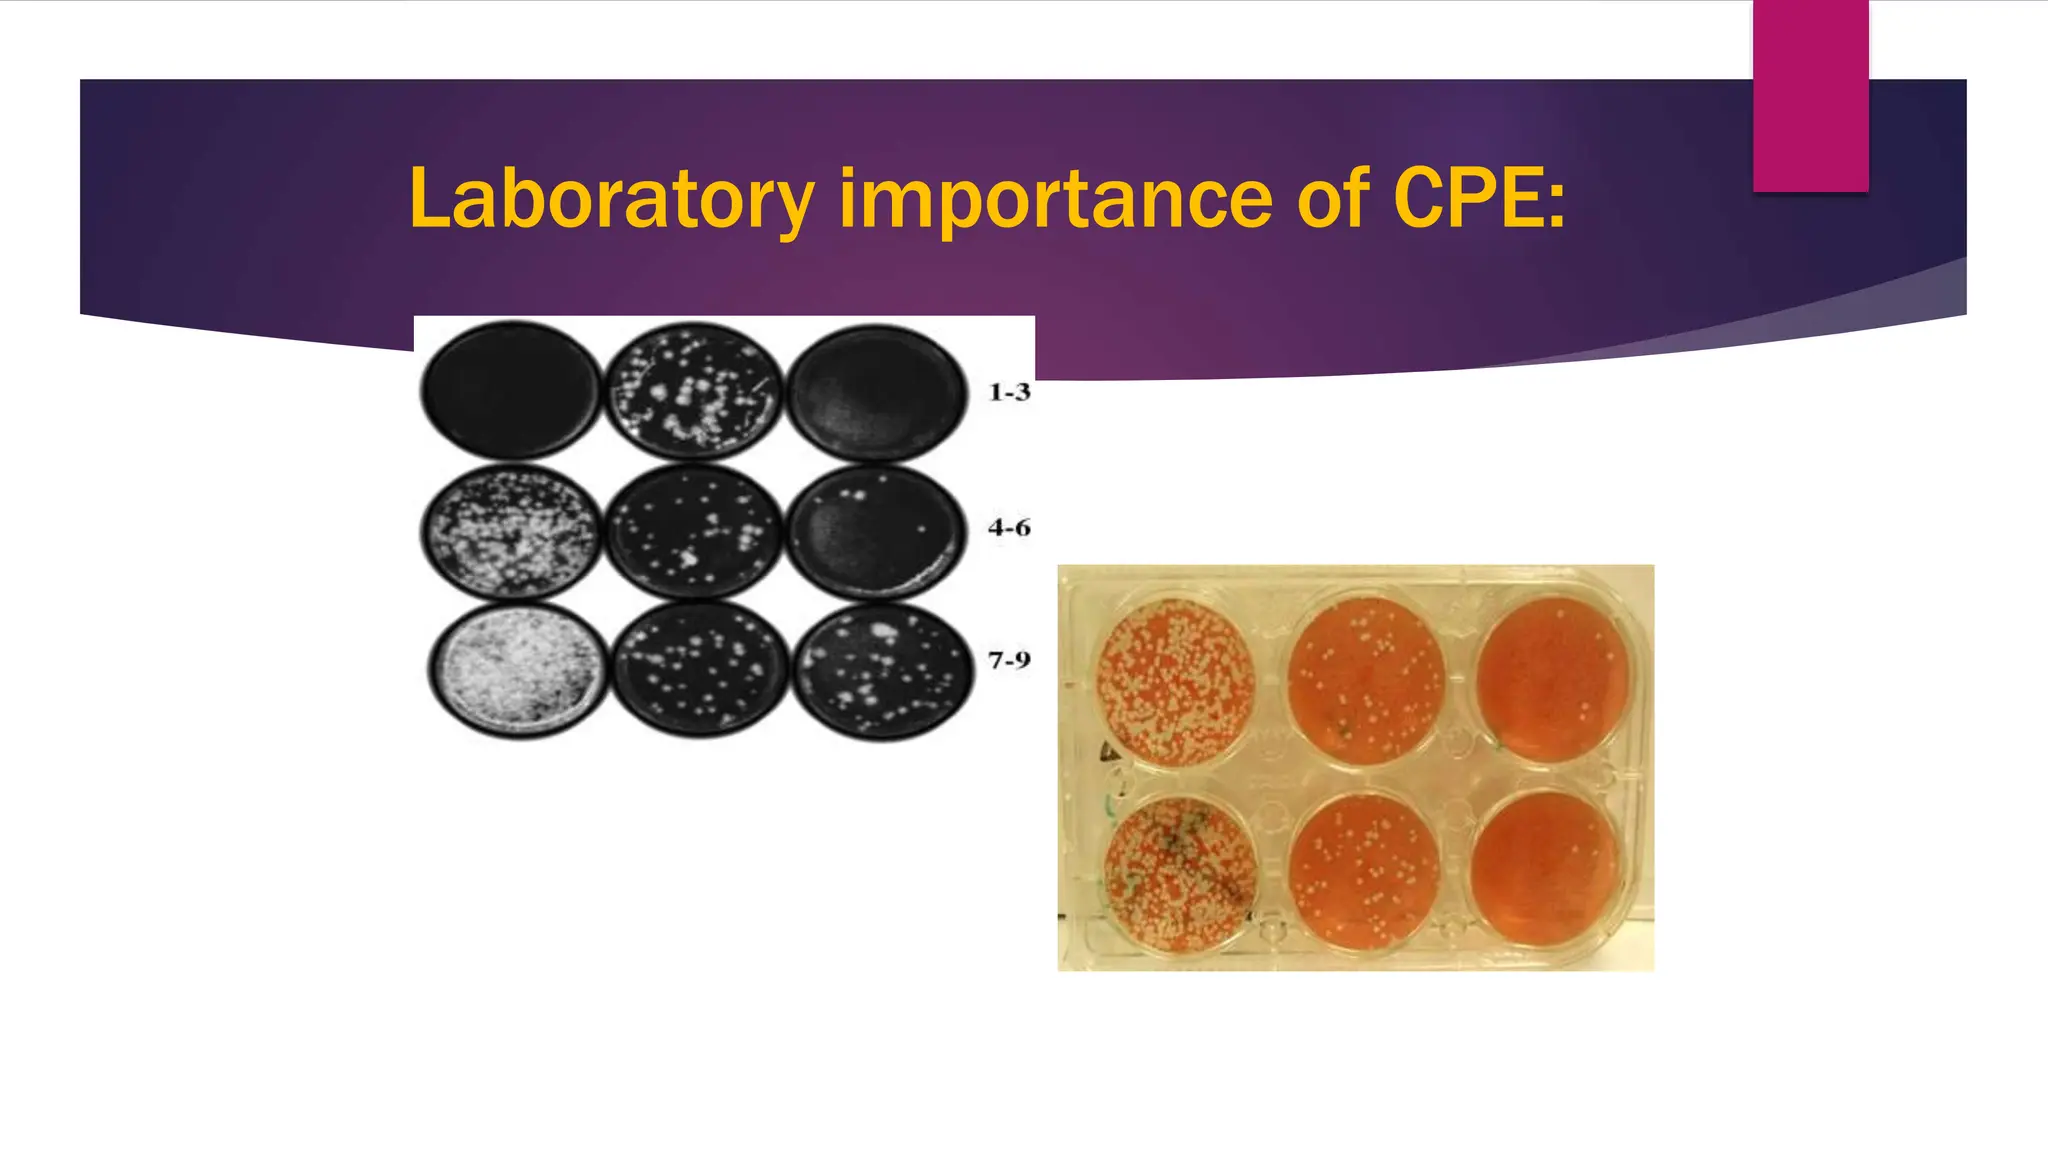
Laboratory importance of CPE:
1
2

The document discusses the pathogenesis of viruses and host defenses, outlining how viruses enter the host, replicate, and cause cellular damage. Key effects of viral infections on host cells include cytopathic effects, malignant transformation, and cell death, along with the immune response that contributes to disease. It also covers viral transmission, persistent infections, and types of viral vaccines for prevention.